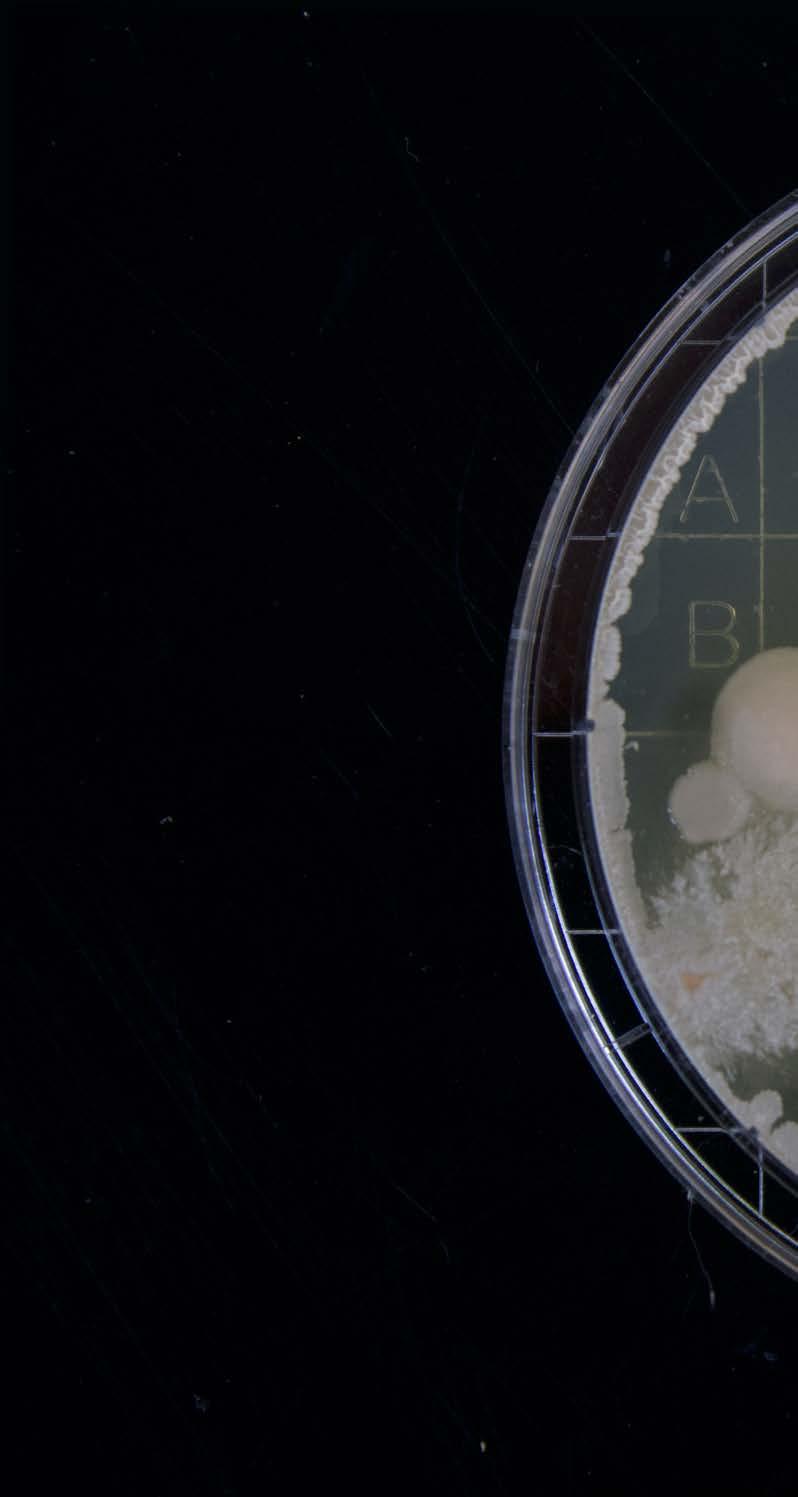

OUR IMPACT OUR FUTURE
EXCELLENCE AT MONASH SCIENCE
GRADUATE RESEARCH

MONASH SCIENCE


EXCELLENCE AT MONASH SCIENCE
GRADUATE RESEARCH


Monash University, a globally recognised researchintensive institution, is dedicated to achieving excellence and making a lasting impact.
With a distinguished position among the top 100 universities worldwide and ranking in the top 3 in Australia, we take great pride in our pioneering research endeavours and entrepreneurial mindset.
At Monash, our students are presented with unparalleled opportunities to learn from worldrenowned faculty and engage in collaborations with leading researchers. As a graduate research student, you become an integral part of a vibrant community that upholds the highest standards of research quality and strives for excellence.

Our impressive track record of producing impactful research that instigates real change in the world ensures that our students are equipped to tackle the challenges of the 21st century with confidence.
Beyond our world-class research, Monash University offers an exceptional learning environment characterised by a diverse and inclusive community, state-of-the-art facilities, and a strong emphasis on career outcomes. We are proud to be a destination where students can flourish academically, personally, and professionally.
If you are seeking a forward-thinking, researchintensive institution that is committed to making a tangible impact and driving transformative change, Monash University is the ideal choice. We warmly invite you to join our community of excellence and embark on a remarkable educational journey with us.

We embrace the theoretical and the experimental. Our research intersects with industry and government. Our scientists play a leading role on the national and international stage, collaborating with major institutions and industries around the world.
Fundamental to our vision is the training of future researchers and leaders who make a vital contribution to the Australian and global communities.
Our students are supervised, nurtured and mentored by scientists who are leaders of their disciplines –we are preparing our graduates to think big and make an impact.
GLOBAL
(QS World University Rankings) AND
OF
• Biological Sciences
• Chemistry
• Mathematics
• Earth, Atmosphere and Environment
• Physics and Astronomy
• School of Science, Monash University Malaysia
# HDR ALUMNI
2,100+ (Since 1975)
(THE World University Rankings)
# TOTAL ALUMNI 42,000+
A VIBRANT,
WORLD-RENOWNEDRANK OF #42 #44

Experience the best of both worlds with your Monash Graduate Research degree, where innovation meets tradition. As part of our renowned research degrees, we proudly offer the Monash Doctoral Program which is designed to increase your research capabilities, elevate your employability and prepare you for life after your PhD.
This distinctive program sets you apart in the dynamic job market, equipping you with a diverse skill set and professional qualities that empower you to make a lasting impact and drive change across multiple domains. Whether your path leads to academia, industry, government, or community, your Monash Doctoral Program journey prepares you to excel and thrive.
Enhance your expertise and stay ahead in the competitive job market with our array of research, career, and professional development modules. These modules can be accessed both online and through face-to-face workshops, providing you with a flexible learning experience. By dedicating a minimum of 120 hours, you can have a significant impact on your career and bring about the change you desire.
Enrol in our Graduate Research Partnership Program and delve into a worldwide concern alongside our esteemed industry partners. Experience a stimulating research training atmosphere and make a significant impact towards driving change. Our interdisciplinary program offers the perfect opportunity to broaden your horizons.
 The Doctoral Program offers distinctive training structures in two modes to enhance the impact and bring about change in your research project.
The Doctoral Program offers distinctive training structures in two modes to enhance the impact and bring about change in your research project.
Our institution also provides Research Master’s Degrees, which involve an intensive two-year full-time study of an independent research problem. By critically analysing and interpreting research, you will be able to contribute to your field of study and facilitate opportunities for further learning.
MPhil
Pursuing a Master of Philosophy will equip you with advanced research skills and specialised knowledge, leading to career opportunities in various sectors.
MSc (Res)


Our Master of Science (Research) program in Monash Malaysia enables you to deepen your understanding of science and enhance your career prospects or pursue further research. Your independent research work will be expected to have a significant impact and change in your chosen field of study, and demonstrate your capacity to conduct research autonomously.


The faculty’s research is at the forefront of innovation and discovery. Our researchers have been involved in some of the biggest scientific outcomes in the world.

• Energy and Materials
• Genetic, Genomics, and Health
• Environmental Change and adaptation
• Evolution of the Earth and Universe
• Solutions for a big data world
• Synthesis for functions
• Mathematical networks, space, and symmetry
• New ways of seeing and understanding the world: State of the art imaging resources
• Centre for Quantitative Finance and Investment Strategies (CQFIS)
• Monash Centre for Atomically Thin Materials (MCATM)
• Centre for Geometric Biology
• Centre for Modelling of Stochastic Systems (CMSS)
• Securing Antarctica’s Environmental Future (SAEF):
Australian Research Council (ARC)
Special Research Initiative
School of Earth, Atmosphere and Environment
School of Chemistry
School of Biological Sciences
School of Mathematics
School of Physics and Astronomy
School of Science (Malaysia)
Here are some additional resources that you may find helpful:
MONASH PHD INDUSTRY ENGAGEMENT monash.edu/graduate-research/partnerships/ internships

MONASH TALENT monash.edu/talent
PhD research internships offer you the opportunity to apply your research skills by working on research projects in industry. Through a variety of pathways, our highly skilled PhD students can undertake internship as part of their research training. Projects are co-designed by industry partners including enterprises, businesses, and government agencies.


YOU CAN BENEFIT FROM:
• Amplify the impact of your research skills and theoretical knowledge through handson application, generating tangible results in practical settings.
• Elevate your employability to new heights by gaining invaluable industry experience alongside your PhD studies.
• Foster extensive networks within the professional sphere, forging connections that can shape your future career and research opportunities.
• Make a meaningful contribution to industry by actively applying your expertise, collaborating with professionals, and addressing real industry challenges.
By choosing to enrol at Monash, you will become a vital part of a university that possesses the necessary international outlook and networks to make a significant impact and create change on a global level.
Our widespread Global presence provides an expansive platform for impactful change. With our joint PhD programs in collaboration with top universities worldwide, you’ll harness the combined expertise and resources of two institutions, earning a prestigious jointly awarded degree. Embrace the power of collaboration and propel your research career to new heights.


• Indian Institute of Technology Bombay (IITB), India
• University of Bath, United Kingdom
• University of Warwick, United Kingdom
• Universität Leipzig, Germany
• Bayreuth University, Germany
• Southeast University, China
INTERESTED
Visit

At Monash University’s Faculty of Science, our PhD program provides an exceptional platform for aspiring scholars to thrive in diverse professional arenas. Our graduates emerge with an advanced understanding of their fields and a comprehensive skill set that equips them for success in academia, industry, and government sectors. We take immense pride in the achievements of our alumni, who continue to make a significant impact across various domains.
Monash University’s Faculty of Science PhD Program empowers graduates for diverse career paths. A substantial number of our alumni excel in academia, securing faculty positions in prestigious universities, where they become influential researchers, educators, and mentors. Our program also equips graduates for success in the private sector, with interdisciplinary research fostering adaptable problem-solving skills for industries. Additionally, our alumni assume leadership roles in government agencies, research institutions, and policy think tanks, actively shaping public policy and addressing complex societal challenges. The remarkable achievements of our alumni across academia, industry, and government sectors reflect the quality and impact of our PhD program.

Here at the Monash Faculty of Science, we prioritise mental health and inclusivity and hope to create lasting change and empower our graduate research students to achieve their academic and personal goals.

Monash University places a significant emphasis on supporting the mental health and inclusivity of our graduate research students. We understand that pursuing advanced studies can be challenging, and we are dedicated to providing comprehensive assistance. Our university recognises the impact of mental well-being on academic success and offers tailored resources and services, including counseling services, stress management workshops, and resilience seminars, to ensure students have access to a safe space for discussion.

We provide comprehensive English language support to foster effective academic communication and promote confidence among all students, regardless of their background.
We are committed to creating an inclusive environment that celebrates diversity and cultural understanding through events, training, and initiatives.
Check your eligibility at: monash.edu/science/ research/graduate-research/ how-to-apply


Are you prepared to fully engage yourself in an innovative research hub and acquire the necessary skills to create tangible influence?
1. Check your eligibility at: monash.edu/science/research/graduate-research/how-to-apply
2. Identify a potential supervisor using Find a Supervisor
3. Contact a research supervisor and complete the Expression of Interest (EoI)
4. Receive an invitation to apply
5. Apply for a scholarship
6. Prepare documentation
7. Submit your application online
APPLY FOR A RESEARCH PROGRAM AND A SCHOLARSHIP
• Applications for admission to a research degree can be made at any time.
• Candidates applying for research scholarships need to submit an application as per the following dates.

1 International 1 September 31 March July – December of the current year
2 Domestic 1 November 31 May July – December of the current year
3 International 1 April 31 August January – June of the following year
4 Domestic 1 June 31 October January – June of the following year
FURTHER INFORMATION
SCIENCE GRADUATE RESEARCH monash.edu/science/research/ graduate-research
INTERNATIONAL STUDENTS monash.edu/study/international
MONASH SCIENCE ONLINE
WEBSITE monash.edu/science
TIKTOK @monash_science
TWITTER @Monash_Science
INSTAGRAM instagram.com/monash_science
FACEBOOK ScienceatMonash
YOUTUBE youtube.com/ScienceMonashUni
CONTACT US
FACULTY OF SCIENCE RESEARCH OFFICE MONASH UNIVERSITY
T +61 3 9905 8870
E SCI-GRADRESEARCH@MONASH.EDU
The information in this brochure was correct at the time of publication (July 2023). Monash University reserves the right to alter this information should the need arise. You should always check with the relevant Faculty office when considering a course. CRICOS Provider: Monash University 00008C. Monash College 01857J.